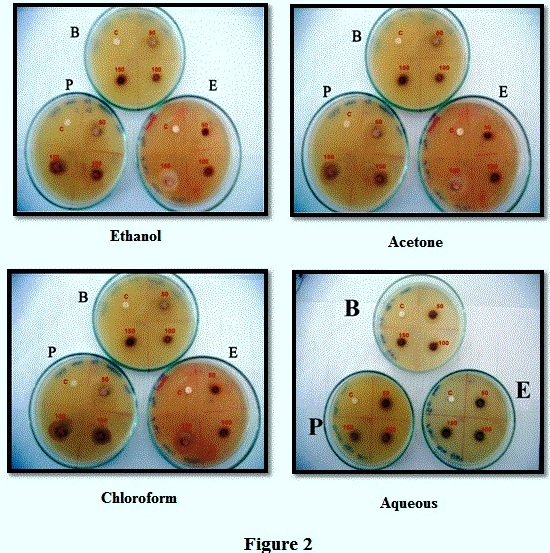

Faculty of Science, Department of Zoology, Annamalai University, Annamalainagar 608002
Email: gopal222@yahoo.com
Received: 11 Mar 2016, Revised and Accepted: 10 Jun 2016
ABSTRACT
Objective: To perform GC-MS analysis and to evaluate the antibacterial activity of Azadirachta indica bark.
Methods: The dried powdered bark of Azadirachta indica (5g) were extracted exhaustively by crude and then fractionated into water, acetone, chloroform and ethanol. The bark ethanol extract was analyzed by GC-MS to identify and characterize the chemical compounds present in the crude extracts.
Results: Ethanol extract was found to contain the highest zone of inhibition against E. coli. In vitro antibacterial activities of ethanol extract were significant and comparable with the other extracts. Hence, the ethanol extract was selected for GC-MS and to identify the presence of 5 compounds in ethanol extracts.
Conclusion: Findings from this study state that the plant Azadirachta indica can be a potent source for treating diverse medicinal properties especially infectious diseases.
Keywords: Antibacterial activity, Disc diffusion method, GC-MS analysis, Azadirachta indica, Bioactive compounds
© 2016 The Authors. Published by Innovare Academic Sciences Pvt Ltd. This is an open access article under the CC BY license (http://creativecommons.org/licenses/by/4.0/)
INTRODUCTION
An antimicrobial is a substance that kills or inhibits the growth of microorganisms such as bacteria, fungi or protozoan. Antimicrobial drugs either kill microbes (microbicidal) or prevent the growth of microbes (microbiostatic). Antibacterial are used to treat bacterial infections and most commonly used drugs. Azadirachta indica is locally called as Neem. Neem tree is the most useful traditional medicinal plant in India. It is a tropical evergreen tree native to Indian subcontinent [2]. It has been used in Ayurvedic medicine for more than 4000 y and each part of the tree has some medicinal properties [1]. Neem tree is the most researched tree in the world. According to world health organization (WHO), more than 80% of the world’s population relies on traditional medicines for their primary health care needs. It is a highly versatile medicinal plant having widespread traditional uses to cure various human diseases [5].
Azadirachta indica belongs to the family Meliaceae commonly called as Neem (English), Vempu (Tamil) and is found throughout India. A medium to large sized tree, grow up to 50 feet (15m) tall and live for 200 y. Neem extracts have a high medicinal value they are used to cure a number of diseases. The bark extract had the potential of controlling gastric hypersecretion and gastroesophageal and gastroduodenal ulcers [4]. Several medicinal plants for their potential antibacterial activity [24]. It has been suggested that aqueous and ethanol extracts from plants used in allopathic medicine are potential sources of antiviral, antitumor and antimicrobial agents [6]. Antimicrobial activities of many plants have been reported by the researchers [23, 3].
Taxonomical classification [9]
Kingdom: Plantae
Order: Rutales
Suborder: Rutinae
Family: Meliaceae
Subfamily: Melioideae
Tribe: Melieae
Genus: Azadirachta
Species: Indica

Fig. 1:
Gas chromatography (“GC”) and Mass Spectrometry (“MS”) make an effective combination for chemical analysis. Gas chromatography (GC) is one of the most widely used techniques. Gas chromatography is also sometimes known as vapor phase chromatography (VPC), or gas-liquid partition chromatography (GLPC). Gas chromatography-mass spectrometry (GC-MS) is an analytical method that combines the features of gas-liquid chromatography and mass spectrometry to identify different substances within a test sample identification of unknown samples. GC-MS is the best technique to identify the bioactive constituents of long chain hydrocarbons, alcohols, acid esters, alkaloids, steroids, amino acid and nitro compounds [17]. Hence, an attempt has been made to evaluate the efficiency of various organic solvents, antibacterial activity and identify the chemical components by GC-MS analysis of crude bark extracts from the Azadirachta indica against selected bacterial strains.
MATERIALS AND METHODS
Chemicals
All other chemicals and solvents used in the experiment were of analytical reagents (AR) grade and distilled water was used throughout the study.
Collection of plant material
Azadirachta indica barks were collected in January 2012 from Jayankondam in Ariyalur district. Tamilnadu, India. The barks were washed thoroughly with water to remove dust and dried under the shade at room temperature for 7days. The dried barks were ground using a mixer to obtain the course powder and kept in an airtight container till further use.
Test organisms
The strains of Bacillus subtilis, Pseudomonas aeruginosa and Escherichia coli were obtained from Department of Microbiology, Annamalai University, Chidambaram, and Tamilnadu, India.
Preparation of plant extracts
The dried powdered bark of Azadirachta indica (5g) was soaked in (15 ml) of solvents (aqueous, ethanol, acetone and chloroform) individually and was kept for solubilization for 5 d with occasional shaking. The fraction was separated using muslin cloth and filter through what man filter paper No-1 and the filtrate was evaporated at 40 °C in a hot air oven. The dried filtrate was then redissolved in 5% of Dimethyl sulphoxide and stored in 4 °C until further use [8].
Disc diffusion method
Antibacterial activity of bark extracts was tested using disc diffusion method [20]. 0.1 ml of the test bacterial culture was aseptically inoculated by spreading them evenly into the surface of nutrient agar plates. 6 mm diameter disc was impregnated with bark extract at different concentrations (50µ, 100µ and 150µ) individually and were placed on it. The inoculated plates were then incubated at 37˚C for 24hours [13]. The diameter of the zone of inhibition formed around the paper disc was measured and expressed in mm [18].
GC-MS analysis
The GC–MS analysis was carried out using a Clarus 500 Perkin–Elmer (Auto system XL) Gas Chromatograph equipped and coupled to a mass detector Turbo mass gold–Perkin Elmer Turbo mass 5.2 spectrometer with an Elite–5MS (5% Diphenyl/95% Dimethylpolysiloxane), 30m x 0.25 µm DF of capillary column. The instrument was set to an initial temperature of 110 ̊C and maintained at this temperature for 2 min. At the end of this period, the oven temperature was a rose up to 280 ̊C, at the rate of an increase of 5 ̊C/min, and maintained for 9 min. Injection port temperature was ensured as 200 ̊C and Helium flow rate as one ml/min. The ionization voltage was 70eV. The samples were injected in split mode as 10:1. Mass spectral scan range was set at 45-450 (m/z). Using computer searches on a NIST Version–Year 2011 were used MS data library and comparing the spectrum obtained through GC–MS compounds present in the plants sample were identified.
RESULTS
The antibacterial activity of Azardirachta indica bark extracts (Aqueous, ethanol, acetone and chloroform) against some bacterial strains. The ethanol extracts showed considerably higher activity than the other extracts. The maximum activity was shown (table 1 & fig. 2) against E. coli followed by Pseudomonas aeruginosa and Bacillus subtilis.
Table 1: Antibacterial activity of crude bark extracts of Azardirachta indica
| Solvent | Zone of Inhibition (mm) |
| Bacillus subtilis | |
| C | |
| Ethanol | - |
| Acetone | - |
| Chloroform | |
| Distilled Water | - |
C–Control,(-)-Noactivity,mm-Milimeter.
The acetone extract had high antibacterial activity against Escherichia coli. Minimum action against Pseudomonas aeruginosa and lesser action against Bacillus subtilis (table 1). The chloroform extract of Azadirachta indica bark showed fairly high activity against Bacillus subtilis followed by Pseudomonas aeruginosa and comparatively lesser activity against Escherichia coli. The aqueous extract did not show any activity against any of the bacterial strains was shown (table 1 & fig. 2).
Fig. 2
GC-MS is one of the best techniques to identify the constituents of long chain, branched chain hydrocarbons, alcohols, acids, esters, etc. The GC-MS analysis of Azadirachta indica bark revealed the presence of five compounds (table 2 & fig. 3) that could contribute the medicinal quality of the plant
Table 2: GC-MS analysis revealed the presence of phytochemical components in ethanolic bark of Azadirachta indica
| S. No. | R/T | Name of the compound |
| 1 | 7.31 | Decosanoic acid,22-trimethyl siloxy)-methyl ester |
| 2 | 7.91 | (1-Benzenesulfonyl-1H-pyrrol-3-yl) acetic acid methyl ester |
| 3 | 8.34 | 1-H-pyrrole-3-propanoic acid,2-(ethoxycarbomyl-4-(2-oxoethyl)-5methyl-ethyl ester |
| 4 | 8.68 | (1-Benzenesulfonyl-1H-pyrrol 3-yl acetic acid,methyl ester), |
| 5 | 9.51 | 3,5-pyridinedicarboxylic acid,2-4-6-trimethyl-diethyl ester. |
Azadirachta indica were used in this present study to evaluate the antibacterial activity. Azadirachta indica were considered as the most effective and showed the maximum zones of inhibition against bacterial strains when compared to the other extracts due to some compounds are present in bark extracts. Hence it was selected for GC-MS analysis. The bark obtained from the ethanol extract of the crude bark extract of Azadirachta indica on GC-MS analysis showed five peaks (fig. 3) indicating the presence of five compounds (1-5) in the bark extract. The fig. 3 shows MS spectra of these peaks having RT 7.31, 7.91, 8.34, 8.68 & 9.51 min respectively.

Fig. 3
DISCUSSION
Azadirachta indica is a very useful traditional medicinal plant in the African-sub continent and each part of the tree has some medicinal properties [1]. In several literature reports [26, 14, 10, 12] in which Azadirachta indica was found to have significant antimicrobial activities against bacterial strains. However, De and Ifeoma [7] reported that at a concentration of 10 mg/ml their crude extracts were unable to inhibit the growth of some bacteria, particularly P. aeruginosa and E. coli. The methanol extract of Azadirachta indica exhibited pronounced activity against Bacillus subtilis (28 mm) [25]. [27] Reported that the ethanol extract of Azadirachta indica showed considerably high activity against Escherichia coli than other extracts. The aqueous and organic extracts from the same plants showed different activities. There are no common rules for this, but in most cases, the organic extracts showed the same or greater activity than the aqueous extracts [19]. The ethanol extracts of the plant materials showed higher antibacterial activity when compared with aqueous extract reported by [21]. John brito [11] shows that the organic extract particularly ethanol exhibited better antibacterial activity. Many researchers are used in this bark [22, 15]. Further studies the GC-MS chromatogram of the bark ethanol extract of Azadirachta indica (fig. 3) showed 5 peaks indicating the presence of five compounds. The chemical compounds identified in the ethanol extract of the bark of Azadirachta indica presented in table 2. GC-MS analysis revealed that the presence of Decosanoic acid, 22-trimethyl siloxy)-methyl ester, (1-Benzenesulfonyl-1H–pyrrol–3-yl) acetic acid, methyl ester, 1-H-pyrrol-3-propanoic acid, 2-(ethoxycarbomyl-4-(2-ethoxy-2-oxoethyl)-5 methyl ethyl ester, Propanoic acid,2 hydroxy-2-methyl ethyl ester & 3,5-pyridine dicarboxylic acid, 2-4-6-trimethyl-diethyl ester. The antimicrobial activity of leaves from Psidium guajava and Azadirachta indica were analyzed by GC-MS. The result showed that 47 bioactive phytochemicals compounds were identified in the ethanol fraction of Azadirachta indica [16]. The present study state that the presence of methyl or ethyl esters of fatty acids can also be considered as characteristics of this plant. From this result, it can be concluded that all these compounds are of pharmacological importance as they possess the properties such as antibacterial anti-diabetic and analgesic.
CONCLUSION
From the present study, it was concluded that the crude ethanol bark extracts of Azadirachta indica have great potential as an antibacterial agent. The outcome of this work has shown that the bark extracts of Azadirachta indica against three bacterial strains. GC-MS analysis showed the existence of various compounds with variable chemical structures. The presence of such variety of phytochemicals may be attributed to the medicinal characteristics of this plant Azadirachta indica. The results of this analysis support the traditional use of Azadirachta indica bark as an antibacterial agent. In several reports, these compounds can be responsible for the contraceptive properties attributed to this plant in popular and traditional medicine.
CONFLICT OF INTERESTS
Declare none
REFERENCES
How to cite this article